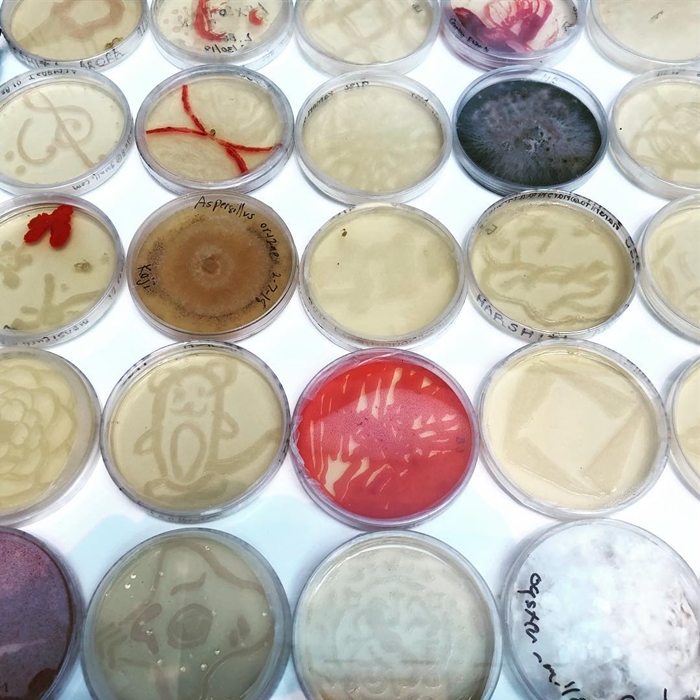

หนึ่งในกลยุทธ์สำคัญของแบรนด์แฟชั่นในยุคนี้คือการโฟกับกับเรื่อง Sustainability หรือการใส่ใจสิ่งแวดล้อมที่ดูเหมือนเป็นช่องทางการทำเงินใหม่ที่สร้างทั้งกำไรและภาพลักษณ์บวกไปพร้อมกับ ช่วงหลังเราจึงเห็นแบรนด์ต่างๆ ออกมาลด-ละ-เลิก บางขั้นตอน บางวัสดุที่ส่งผลกระทบต่อสิ่งแวดล้อม รวมถึงการสร้างสรรค์สิ่งใหม่ๆ ที่เป็นมิตรกับสิ่งแวดล้อมมากขึ้น

ล่าสุดเป็นคิวของ Hermes แบรนด์ที่ขึ้นชื่อว่าเป็นผู้เชี่ยวชาญด้านเครื่องหนังระดับโลก ได้ออกมาเปิดเผยโปรเจกต์สำคัญที่ได้ซุ่มทำกับบริษัท MycoWorks ของอเมริกาซึ่งใช้เวลามากกว่า 3 ปีในการผลิตหนังเทียมโดยใช้เทคนิคการเพาะเส้นใยจากเห็ด หรือ Fine Mycelium ให้กลายเป็นแผ่นหนังที่สามารถนำมาใช้ในการผลิตเครื่องหนังต่างๆ โดยมีความคงทนและคุณภาพสูงแบบเดียวกับหนังสัตว์ รวมถึงยังเป็นมิตรกับสิ่งแวดล้อมมากกว่าหนังเทียมที่ผลิตจากพลาสติก PU

Hermes ได้ทำการเปิดตัวไอเท็มชิ้นแรกที่ใช้หนังเทียม Fine Mycelium ในการผลิต ซึ่งเรียกหนังชนิดนี้ว่า “Sylvania” โดยนำไปผลิตกระเป๋าเดินทางรุ่น Victoria โดยทาง Hermes เตรียมวางขายปลายปีนี้ รวมถึงเตรียมพัฒนาหนังเทียมจากเห็ดนี้ไปใช้กับสินค้าอื่นๆ ต่อไป

Source : mycoworks.com, complex.com
